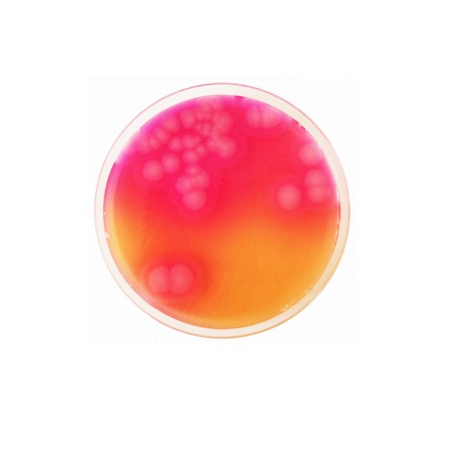
product

BCP Glucose Agar is specifically designed to identify organisms capable of glucose fermentation, a key characteristic of the Enterobacteriaceae family. The medium contains Enzymatic Digest of Gelatin and Beef Extract, which provide the essential nitrogen, vitamins, and minerals required for bacterial growth. Glucose is the fermentable carbohydrate and primary energy source. Differentiation is achieved through the pH indicator Bromocresol Purple. Microorganisms that ferment glucose produce organic acids, lowering the pH of the medium and changing the color of the colonies and the surrounding agar from purple to yellow. This medium is particularly useful as a confirmatory step for colonies isolated from selective media such as VRBG Agar.
Advantages
- ISO Standard Compliance: Strictly formulated according to ISO 21528 for the detection and enumeration of Enterobacteriaceae.
- Clear Differentiation: The distinct color change from purple to yellow provides an unequivocal visual confirmation of glucose fermentation.
- High Sensitivity: Optimized nutrient balance ensures the recovery and metabolic activity of a wide range of enteric bacteria.
- Standardized Confirmation: Ideal for the secondary identification of bile-tolerant Gram-negative bacteria in food quality control.
- Versatile Application: Can be used for both the pour-plate method and surface inoculation.
Technical specifications
| Catalogue number |
1320 |
| Brand |
Condalab |
| Application |
Differentiation of bacteria based on glucose fermentation (ISO 21528) |
| Typical Composition (g/L) |
Enzymatic Digest of Gelatin (5.0); Beef Extract (3.0); Glucose (10.0); Bromocresol Purple (0.02); Bacteriological Agar (15.0) |
| Final pH (at 25 °C) |
7.0 ± 0.2 |
| Preparation |
33.02 g/L |
| Storage Temperature |
2 – 25 °C |
Available packaging options
| 1320 |
500 g plastic bottle |